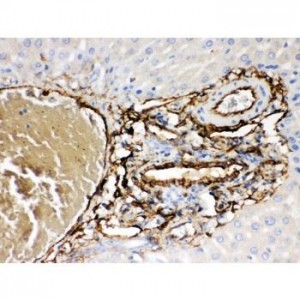
ABCB4  Antibody

Immunohistochemistry (IHC)
Showing 1057–1068 of 1068 resultsSorted by latest
-

Actin Antibody
$330.00 Add to cart -

ACE Antibody
$365.00 Add to cart -

ABCB6 Antibody
$330.00 Add to cart -
ABCB4 Antibody
$365.00 Add to cart -

ABCB11 Antibody
$330.00 Add to cart -

ABCB11 Antibody
$365.00 Add to cart -

AAMP Antibody
$365.00 Add to cart -

5HT3A receptor Antibody
$330.00 Add to cart -

5HT2A Receptor Antibody
$330.00 Add to cart -

5HT1A Receptor Antibody
$330.00 Add to cart -

53BP1 Antibody
$330.00 Add to cart -

5 Lipoxygenase Antibody
$330.00 Add to cart